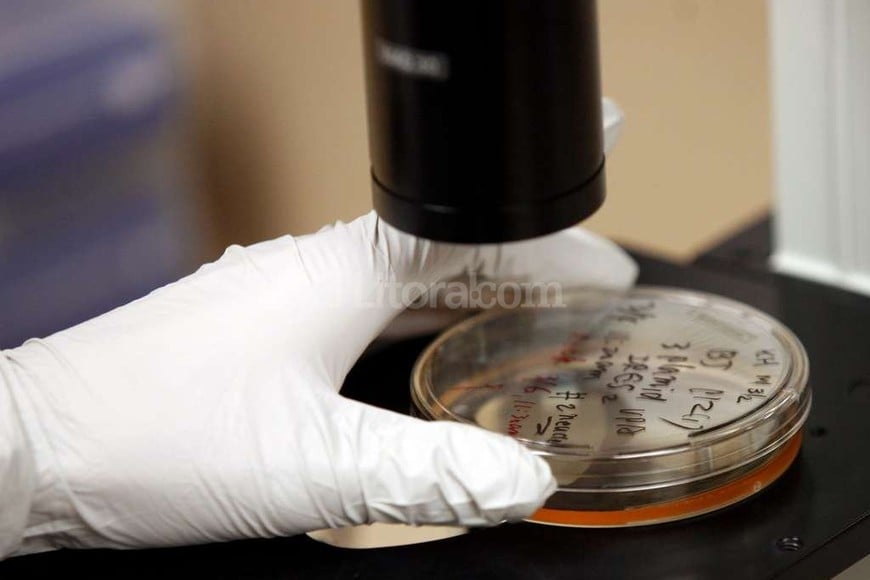
ELLITORAL_165341 | Flavio Raina Los adelantos en genética molecular y las ciencias de la vida se aceleran en combo con las tecnologías de la información y definen un nuevo horizonte para la investigación científica.

Gastón Neffen

Es lo que piensa el científico norteamericano Ryan Bethencourt. Está convencido de que se viene una revolución a partir de la “biología digital” y que Santa Fe tiene grandes oportunidades

Gastón Neffen
Ryan Bethencourt no es tecnofóbico, no padece el Síndrome de Frankenstein y Wikipedia lo define como un “biohacker”, un movimiento global que quiere democratizar el acceso a la ciencia, la biología y la biotecnología, para que no esté encerrada en los laboratorios de las corporaciones, las universidades y los centros de investigación públicos.
Vive en Oakland —en el área de la bahía de San Francisco en Estados Unidos—, una ciudad que le encanta porque está rodeado de artistas y hackers. Tiene 37 años y contagia entusiasmo. Estudió medicina, genética molecular y biociencia en universidades prestigiosas (Yale, Stanford y Cambridge). Trabajó en la industria biofarmacéutica, fundó laboratorios y ahora es el director de IndieBio, una empresa aceleradora e inversora en bioemprendimientos.
Vino a Santa Fe para dar una conferencia en la jornada BioArgentina, que se realizó esta semana en el puerto. También para elegir empresas y proyectos, con base biotecnológica, en los que invertir “capital semilla”, el financiamiento base para que una futura compañía pueda despegar.
En una entrevista con El Litoral, Bethencourt dijo que “hay un gran potencial en la alianza entre la biotecnología y la informática”, en la fusión entre tecnologías de la información, las ciencias de la vida y la biología digital.
— ¿En qué sectores la Argentina tiene oportunidades para desarrollar biocompañías?
— Hay tres rubros muy claros. El primero es la medicina y la biofarmacéutica. La Argentina es líder regional en América Latina y debería serlo en el mundo. Lo que sucede es que todavía no llegó ese punto de quiebre, en el que las compañías locales se convierten en globales. En todo lo que es medicina regenerativa y biofármacos hay oportunidades reales para este país.
— ¿Por qué la Argentina puede crecer en esta área?
— Porque aquí hay muy buena ciencia. Hay conocimiento científico de base. Y aunque no siempre está el dinero, cuando los científicos están motivados y tienen una visión suelen encontrar el camino para materializar ideas innovadoras.
— ¿Cuáles son los otros campos con potencial en la Argentina?
— La agricultura y el desarrollo de biomateriales. El sector agrícola argentino es referente mundial en el uso de biotecnología aplicada a los cultivos. Es uno de los tres líderes globales, junto a Estados Unidos y Brasil, en el uso de semillas genéticamente modificadas. Hay científicos locales, que lograron desarrollos interesantes y probablemente van a poder seguir innovando a partir de las tecnologías para editar genes y procesar el ADN, que se aplican a las plantas.
— ¿Cómo estimula una ciudad el desarrollo de bioempresas?
— Hay que comenzar por las personas y la comunidad, no construyendo edificios. Se necesita acceso a los laboratorios, pero lo más importante es conectar la biociencia con la comunidad. Es fundamental que todos aprendan sobre biotecnología y ciencia, porque uno nunca sabe de dónde llegan los visionarios, pueden ser artistas, políticos, jóvenes, y no sólo científicos. En la Argentina hay muchos estudiantes que pueden desarrollar estas compañías pero necesitan aprender o conectarse con emprendedores que puedan definir un modelo de negocios y contactar con inversores.
— ¿Cuáles son las dificultades que suelen enfrentar los proyectos?
— Lo que suele sucede es que al principio se necesita financiamiento y acceso a los laboratorios, que suelen ser un filtro porque les plantean a los potenciales innovadores que ellos no pueden garantizar los recursos para usar ese laboratorio donde necesitan investigar. Los mentores juegan un rol clave para encontrar alternativas a estos desafíos fundacionales.
— En la actualidad, ¿hay más estudiantes de biotecnología, biología y genética?
— Sí. Es una tendencia mundial y una diferencia con otras épocas en las que todos querían ser médicos, abogados o arquitectos.
— ¿Qué piensa sobre el debate público acerca del uso de biotecnología en la salud y en la producción de alimentos?
— La tecnología siempre gana, cuando supone un adelanto y una innovación se termina imponiendo. Y esto sucede desde que el hombre aprendió a dominar el fuego. Cuando se inventaron los telares industriales, hace dos siglos, había gente que los quería destruir porque se perdían empleos, pero siempre se encuentra la forma de crear nuevos trabajos y avanzar. Nadie quiere destruir esas fábricas ahora. Cuando se hicieron los primeros transplantes de pulmón, había gente que decía que eran desagradables y los comparaban con el personaje de la novela Frankenstein. Hoy se salvan miles de vidas gracias a los trasplantes y a todo el mundo le parece maravilloso que se pueda trasplantar un corazón. El debate sobre los alimentos genéticamente modificados también se va a ir diluyendo.
— ¿Por qué?
— Los alimentos genéticamente modificados son seguros y los necesitamos para alimentar a los 3.000 millones de personas más que van a vivir en el planeta hacia el 2050. Además, las nuevas semillas, que tienen genes que protegen a esos cultivos contra los ataques de insectos y las enfermedades, también implican un menor uso de plaguicidas y de fungicidas, lo que reduce el impacto ambiental de la agricultura. Además logran un uso más eficiente del agua, otra cuestión estratégica.